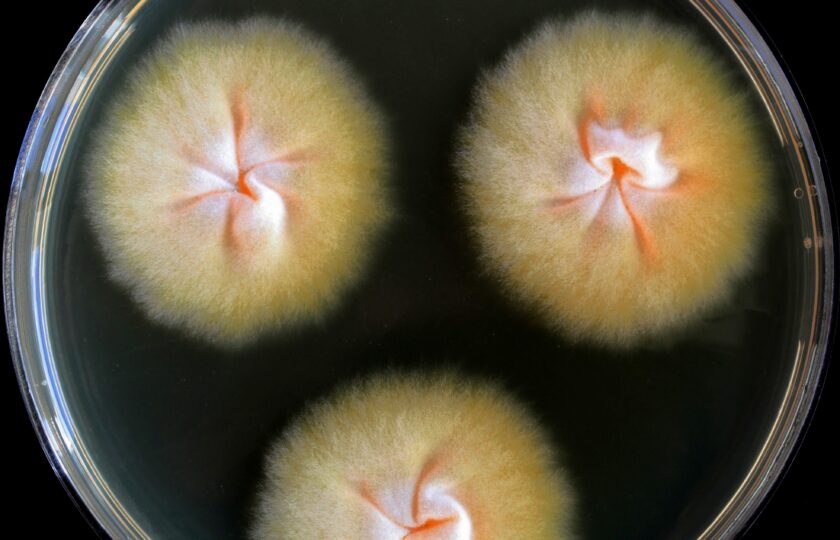

Several years ago, scientists from Laboratory of Fungal Genetics and Metabolism described the fungus Trichophyton benhamiae var. luteum as the cause of an epidemic that affected many children across Europe. The disease, which is transmitted from guinea pigs to humans, manifests itself as a severe rash and inflammation of the skin, most commonly on the face or hands.
In a new study, IMIC team focused on the reason for the easy spread of this infection. They described that the fungus uses toxic substances that can weaken the host’s immune response, thereby facilitating the transmission of the fungus between guinea pigs, from guinea pigs to humans, and between humans themselves.
Although Trichophyton benhamiae var. luteum has close relatives in Europe and America, these spread much more slowly and only rarely cause infections. The “luteum” variant therefore appears to be evolutionarily exceptionally adapted to transmission between guinea pigs and humans.
“We found that the genes associated with secondary metabolites (compounds that are not directly engaged in normal growth and development but do have some ecological functions) are significantly more active in this skin pathogen,” explains the first author of the study, Lenka Machová from the IMIC CAS.
In addition to laboratory experiments, the team also used a skin infection model on tissues that mimics the real conditions in mouse skin. “This allowed us to find out how the fungus reacts in its natural environment,” adds research team leader Adéla Wennrich from IMIC CAS.
According to Miroslav Kolařík, head of the Laboratory of Fungal Genetics and Metabolism at IMIC, this is an important contribution to understanding the mechanisms that enable certain species of dermatophytes to spread rapidly and infect new hosts.
“Such knowledge is key to the development of new diagnostic tools and treatment strategies—as well as to the protection of public health,” says the scientist.
Further, research will now focus on the nature of some of these toxic substances and how exactly they affect human cells. A better understanding of their mechanism could enable targeted intervention in this virulence factor in the future, for example in the development of new treatment approaches.
PUBLICATION
Comparative gene expression analysis in closely related dermatophytes reveals secondary metabolism as a candidate driver of virulence; Machová L, Kostovčík M, Švec K, Hubka V, Kolařík M, Wennrich A.; Microbiol Spectr (2025); DOI: 10.1128/spectrum.01383-25
Contact
Mgr. Adéla Wennrich, Ph. D.:
Mgr. Lenka Machová:


Pathogen Trichophyton benhamiae (left) and human infection (author: Adéla Wennrich)